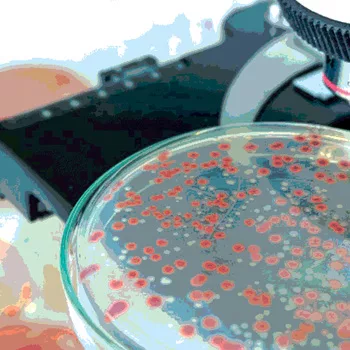

A Look at the Microbiology Testing Market
Welcome to Food Safety Insights—a collaboration between the industry experts at Food Safety Magazine and the food safety market experts at Strategic Consulting Inc. (SCI) to bring you the latest market research, insights and trends in food safety, analytical testing, diagnostics, laboratory services, sanitation and related topics in quality and safety testing and assurance in the food and beverage industry.
Each column will review a market topic in food safety and provide up-to-date facts and figures not available anywhere else. Our insights come from primary research conducted regularly with food processors and laboratories throughout the United States and around the world, from SCI’s primary market research data and from Food Safety Magazine’s in-depth knowledge and resource network.
This article reviews the overall microbiology testing market, enabling you to align these trends with your business strategies and optimize your food safety system, no matter where you are in the supply chain. Subsequent columns will address similar topical issues and data and present an analysis of what it means for the food industry as a whole.
Micro Testing
In 2016, the global food microbiology market totaled 1.14 billion tests, up from 966 million tests in 2013 (and 738 million tests in 2008).
Total viable organisms, coliforms/Escherichia coli, yeast/mold and Staphylococcus compose the routine microbiology tests generally used in the food processing industry as indicators of the presence and/or levels of microorganisms in a plant or food product. In 2016, these routine tests were estimated to account for more than 860 million tests, 75.4 percent of all microbiology tests conducted, up from 742 million tests and 76.8 percent of all tests performed in 2013 (Figure 1). This reduction in the proportion of routine tests is not for lack of growth in the category, which we estimate is growing at approximately 5.0 percent annually, but is more likely from the impact of the much faster growth in the volume of pathogen testing. 
Testing for pathogens makes up the remaining volume of microbiology testing; in 2016, we estimate that more than 280 million tests for pathogens, or 24.6 percent of microbiology test volume, will have been performed, up from 224 million tests and 23.2 percent in 2013, accounting for 7.7 percent growth (compound annual growth rate, or CAGR).
That pathogen test volumes are growing faster than microbiology test volumes in general is a continuation of a long-term trend. In 1998, for example, SCI reported routine tests as 86.3 percent of total test volume. Growth of routine microbiology test volumes has continued at a steady rate since then, just at a significantly lower rate than the volume of testing for pathogens, which has received a far greater focus.
Of the estimated 280 million tests for pathogens in 2016, Salmonella was the target in approximately 120 million tests, which represents around 43 percent of pathogen testing. Listeria/Listeria monocytogenes tests totaled about 115 million tests, or 41 percent, and pathogenic E. coli is estimated to be 14 percent of pathogen test volume, with approximately 40 million tests conducted. Campylobacter represented another roughly 4–5 million tests annually.
Market Value
The total market value for microbiology testing in the food sector has grown over the past 5 years at a 7.1 percent CAGR. The market value of micro testing has grown at a higher rate than the test volume rate, based on modestly increasing prices, a greater proportion of higher-priced pathogen tests and a shift from traditional methods to higher-priced rapid methods, particularly for pathogens (Figure 2). From a market-value standpoint, routine testing accounted for roughly 49 percent of the global market value of microbiology testing in 2016, at approximately $1.7 billion, based on an average cost per test (ACT) of around $2.00.1 Pathogen testing, with its higher ACT of roughly $6.40–$6.50,1 accounts for 51 percent of total market value, or $1.8 billion (Figure 3). The growth in market value of pathogen testing relative to routine testing has continued to dramatically expand over the last two decades. In 1998, for example, SCI estimated that the market value of pathogen testing was only 38.8 percent of total market value. The higher proportional volume of higher-priced pathogen tests and the faster shift from traditional to higher-priced instruments and rapid diagnostics for pathogens are the main drivers in this market-value shift.


Clearly, these changing dynamics in the food microbiology analytical business will continue to create opportunities and risks for all the players. Understanding this changing landscape will be of paramount importance to anyone involved in food testing, whether as a buyer or a seller. The success and business sustainability of diagnostics companies and food laboratories will depend on how they interpret these changes and the strategic moves they make to navigate these changing conditions. Food processors that understand these dynamic conditions will also be able to take advantage to lower their costs and improve the capabilities and performance of their testing programs.
Conclusions
We are pleased to introduce Food Safety Insights as your resource to get the best actionable data to guide your business decisions. If you are a diagnostic company or laboratory, this may mean developing a better understanding of your customer’s needs, feedback to test product and service offerings, or data to better refine your strategic marketing plans. If you are a food processor, this may mean data to benchmark your program and processes, measure against best practices or find market pricing and competitive data.
This collaboration is needed in a market as large, complex and fast-changing as food safety. The environment is evolving, not only in terms of regulations but also in terms of enforcement processes. New, more sensitive technologies can detect fewer bacterial cells and lower concentrations of contaminants, while advances such as whole-genome sequencing are changing the game on traceability of these findings. These factors will force suppliers to improve their product and service offerings and manufacturers to stay at the cutting edge of best practices or risk being replaced by those who do. A thorough understanding of market and competitive factors is of key importance in determining your strategy and properly directing your efforts and investments.
In the next column, we’ll detail how food safety testing and diagnostic practices and markets differ in different regions of the world and how you can use this information in the international development of your business.
Bob Ferguson is the managing director of Strategic Consulting Inc. and can be reached at foodsafetyinsights@gmail.com or on Twitter at @SCI_Ferguson.
Reference
1. These price averages are based on the calculation of the average price of a diagnostic test, not including any ancillary costs such as labor, utilities and disposables that may also be required to run the test. Also, these averages do not represent any particular diagnostic, as there is a wide disparity in test costs. The ACT also does not account for the full market value of the price of a test if, for example, it was purchased from a food contract laboratory.
Looking for quick answers on food safety topics?
Try Ask FSM, our new smart AI search tool.
Ask FSM →








